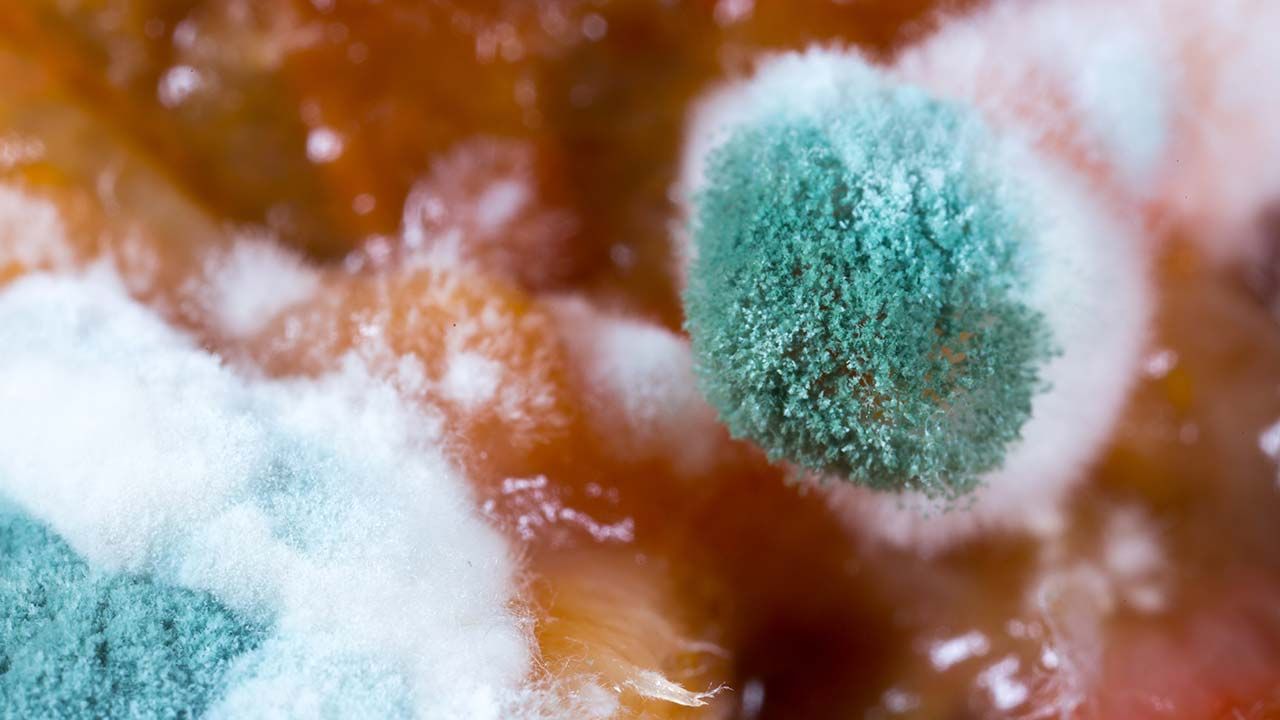

Comprehensive Mold & VOC Testing for a Healthier Home
Whether you’ve recently purchased a new property, have a mold allergy, or have experienced a flood and require mold air or volatile organic compounds testing in or around Gainesville, GA, then Indoor Air Quality Services can help. Our team has 10+ years of experience with mold indoor air quality (IAQ) testing and will provide precise results fast. We’ll identify any issues or risk factors and work with you to understand the results of your IAQ mold test so that you can make informed decisions for you and your family. If you’ve been experiencing mystery allergy-like symptoms, VOCs could be to blame. For all your air quality needs, think Indoor Air Quality Services.
In addition to serving Gainesville, GA, Indoor Air Quality Services operates throughout Gwinnett County, including in and around:
- Marietta, GA
- Atlanta, GA
- Lawrenceville, GA
- Decatur, GA
- Norcross, GA
- Peachtree, GA
- Peachtree Corners, GA
- Alpharetta, GA
- Duluth, GA
For all your VOC testing needs, contact our team today. Call Indoor Air Quality Services at (770) 363-2670


Call and Schedule Your IAQ Mold Test Before It's Too Late
Inspect. Test. Report. Guidance
10+ YEARS OF EXCELLENCE
With more than 10 years of experience, you know you can trust our team for top service. We offer precision air testing and fast results and quick improvement solutions. In addition to offering quick testing, we'll also consult with you around the results. In other words, we'll make sure you understand the report and offer expert guidance when applicable.




